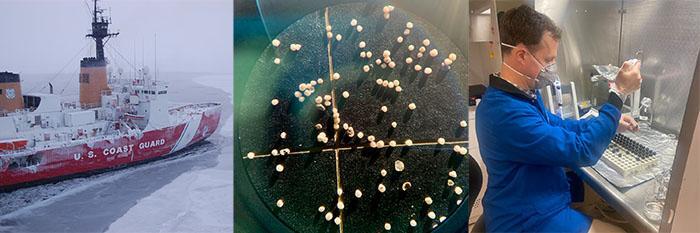

Ottantadue chilometri d’acqua separano oggi la Siberia dall’Alaska, ma sotto queste acque agitate si nasconde una delle storie geologiche più straordinarie del pianeta. Lo Stretto di Bering non è solo il confine liquido tra due superpotenze, come Sara Marsico ha brillantemente raccontato su Vitamine vaganti: è il risultato di milioni di anni di processi geologici che hanno plasmato non solo il paesaggio, ma il destino stesso dell’umanità.
Come geologa, quando osservo una carta dello Stretto di Bering vedo più che una linea di confine. Vedo la memoria liquida di un ponte di terra che ha cambiato la storia del mondo, l’eredità di cicli glaciali che si sono alternati per centinaia di migliaia di anni, e soprattutto la prova tangibile di come la Terra continui a modellare le vicende umane anche quando non ne siamo consapevoli.
Lo Stretto di Bering è, geologicamente parlando, un’area poco profonda che collega due grandi masse continentali. Con una profondità media che non supera i 30-50 metri, rappresenta la parte più superficiale di una vasta piattaforma continentale che si estende dal Mar Glaciale Artico fino all’Oceano Pacifico.
Questa caratteristica batimetrica apparentemente banale nasconde in realtà un meccanismo geologico di straordinaria importanza: la “valvola” che regola gli scambi oceanici tra Pacifico e Artico. Quando, nel corso delle ere geologiche, il livello del mare si è abbassato di poche decine di metri, la soglia è emersa, interrompendo la circolazione oceanica globale e trasformando radicalmente il clima planetario.
Il substrato geologico dello stretto è costituito da rocce sedimentarie del Cretacico e del Cenozoico, deformate dai complessi eventi tettonici che hanno interessato questa regione per centinaia di milioni di anni. La piattaforma continentale su cui poggia rappresenta infatti la zona di sutura tra la placca nordamericana e quella eurasiatica, un confine geologico quanto lo è oggi quello politico.
La vera protagonista della storia geologica di questa regione è la Beringia, quel vasto ponte di terra emersa che durante le glaciazioni quaternarie collegava fisicamente l’Asia all’America settentrionale. Contrariamente a quanto spesso si immagina, non si trattava di una sottile striscia di terra, ma di una regione vastissima che si estendeva per oltre 1.000 chilometri da nord a sud.
Le ultime ricerche hanno rivoluzionato la nostra comprensione della cronologia della Beringia.

Utilizzando sofisticate analisi degli isotopi dell’azoto in sedimenti artici, gli scienziati hanno ricostruito con precisione i livelli marini degli ultimi 46.000 anni, scoprendo che l’ultimo ponte di terra si formò molto più tardi di quanto si pensasse: appena, si fa per dire, 35.700 anni fa.
Questa tempistica geologica così precisa ha implicazioni straordinarie per la comprensione delle migrazioni umane. Significa che i primi gruppi di cacciatori-raccoglitori attraversarono la Beringia appena questa si formò, suggerendo una straordinaria capacità di adattamento e una pressione demografica che spingeva costantemente verso nuovi territori.
Dal punto di vista paleoclimatico, la Beringia rappresentava un ambiente unico: una vasta prateria di tundra-steppa che fungeva da rifugio ecologico durante le fasi più rigide delle glaciazioni. Mentre gran parte del Nord America era coperta da calotte glaciali spesse chilometri, questa regione rimaneva relativamente temperata grazie all’influenza moderatrice dell’Oceano Pacifico.

Le condizioni ambientali della Beringia erano caratterizzate da un clima secco e freddo, ma non estremo. Le temperature estive erano solo 3-5°C più basse di quelle attuali, sufficienti a sostenere una ricca fauna di grandi mammiferi: mammut, rinoceronti lanosi, bisonti della steppa, cavalli selvatici. Questa megafauna rappresentava una risorsa alimentare fondamentale per le popolazioni umane che attraversavano il ponte di terra.
Altre teorie ipotizzano che le popolazioni asiatiche non siano passate al centro della Beringia, ma si siano spostate lungo le spiagge delle coste; poco cambia ai fini del risultato.
La fine dell’era glaciale, iniziata circa 19.000 anni fa, segnò anche l’inizio della fine per questo ponte tra i continenti. L’innalzamento del livello marino, causato dalla fusione delle grandi calotte glaciali, procedette però in modo graduale e discontinuo. Lo stretto si riaprì definitivamente solo 11.000 anni fa, isolando per sempre l’Asia dall’America.
Questo processo di “annegamento” della Beringia non fu uniforme. Le ultime terre emerse rimasero visibili ancora per millenni sotto forma di isole, creando un arcipelago che facilitava ancora i contatti tra i due continenti. Solo quando anche queste ultime isole scomparvero sotto le acque, la separazione divenne definitiva.
Oggi, le uniche terre emerse nel cuore dello Stretto di Bering sono le due piccole isole Diomede, distanti appena 4 chilometri ma separate dalla Linea Internazionale del Cambio di Data. Dal punto di vista geologico, queste isole rappresentano gli ultimi affioramenti del substrato roccioso pre-quaternario della regione.
La Grande Diomede (russa) e la Piccola Diomede (americana) sono costituite principalmente da rocce sedimentarie mesozoiche, testimoni silenziose di quando questa regione era sommersa da mari tropicali. Le loro scogliere scistose e i depositi glaciali che le ricoprono raccontano la storia degli ultimi cicli glaciali, quando erano semplici nunatak — la sommità di un rilievo nascosto — emergenti da una distesa di ghiaccio e tundra.

La storia geologica dello Stretto di Bering è tutt’altro che conclusa. La regione si trova infatti all’intersezione di sistemi tettonici ancora attivi: la subduzione della Placca Pacifica sotto quella Nordamericana genera ancora oggi un’intensa attività sismica e vulcanica lungo l’arco delle Aleutine.
I geologi hanno identificato nella regione dello stretto l’esistenza di un “blocco di Bering” indipendente, in movimento relativo rispetto alla placca nordamericana. Questa microplacca, delimitata da sistemi di faglie attive, è responsabile della frequente attività sismica che caratterizza la zona.

Comprendere la geologia dello Stretto di Bering non è solo un esercizio accademico: ha implicazioni dirette per il futuro della regione. Il cambiamento climatico sta modificando rapidamente gli equilibri fisici che hanno caratterizzato questa area per millenni.
L’innalzamento delle temperature artiche sta causando l’erosione accelerata dei fondali poco profondi dello stretto. Studi recenti documentano un approfondimento di oltre un metro sul lato verso l’Alaska, un fenomeno che potrebbe alterare significativamente i flussi oceanici e le correnti che attraversano la regione.
Allo stesso tempo, la riduzione del ghiaccio marino artico sta aprendo nuove prospettive per la navigazione commerciale, trasformando quello che per millenni è stato un ostacolo invalicabile in una potenziale autostrada marittima. Questo ha profonde implicazioni geopolitiche che si innestano su fondamenta geologiche antiche di milioni di anni.
La geologia dello Stretto di Bering ci insegna che i confini politici di oggi si poggiano su processi naturali che hanno plasmato il nostro pianeta nel tempo. Quegli ottantadue chilometri d’acqua che separano Russia e Stati Uniti non sono solo una linea sulla carta geografica: sono la superficie liquida di una storia che inizia nel profondo del tempo geologico e continua a scriversi ogni giorno sotto i nostri piedi.
Come accade spesso quando si studia la Terra, anche la geologia dello Stretto di Bering ci ricorda che passato, presente e futuro sono intimamente connessi in modi che spesso sfuggono alla percezione umana, ma che continuano a influenzare profondamente il nostro destino collettivo.
In copertina: foto da satellite dello stretto di Bering: a sinistra la Russia a destra gli Stati Uniti. Da Nasa.
***
Articolo di Sabina Di Franco

Geologa, lavora nell’Istituto di Scienze Polari del CNR, dove si occupa di organizzazione della conoscenza, strumenti per la terminologia ambientale e supporto alla ricerca in Antartide. Da giovane voleva fare la cartografa e disegnare il mondo, poi è andata in un altro modo. Per passione fa parte del Circolo di cultura e scrittura autobiografica “Clara Sereni”, a Garbatella.
